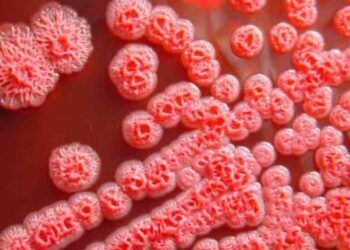
nhung bieu hien lam sang thuong gap cua benh whitmore Dấu hiệu thường gặp khi mắc bệnh Whitmore Những biểu hiện lâm sàng thường gặp của bệnh Whitmore

Ngày 10/11, Cục Y tế dự phòng (Bộ Y tế) có công văn khẩn gửi Sở Y tế Thanh Hóa và Đắk Lắk về việc tăng cường phòng bệnh Whitmore.
Theo báo cáo của Bệnh viện Nhi Trung ương và của hệ thống giám sát bệnh truyền nhiễm, vừa ghi nhận một số trường hợp mắc bệnh Whitmore (tên gọi khác là bệnh Melioidosis) do vi khuẩn Burkholderia pseudomallei gây ra, trong đó có 2 trường hợp là trẻ em tại thị xã Nghi Sơn, huyện Nông Cống, tỉnh Thanh Hóa và 1 trường hợp là người lớn tại huyện Krông Pắc, tỉnh Đắk Lắk.
Đây tuy là bệnh không thường gặp, không gây thành dịch, nhưng bệnh cảnh thường tiến triển nặng, có tỷ lệ tử vong cao, nhất là ở những đối tượng có nguy cơ cao. Điều kiện vệ sinh môi trường bị ô nhiễm sẽ tạo điều kiện thuận lợi cho vi khuẩn sinh sôi, phát triển, nên có thể tiếp tục ghi nhận thêm nhiều trường hợp mắc bệnh Whitmore.
Các biện pháp phòng bệnh chủ yếu là đảm bảo vệ sinh cá nhân, vệ sinh môi trường, sử dụng bảo hộ lao động khi làm việc có tiếp xúc với đất, nước bị nhiễm khuẩn hoặc trong môi trường không đảm bảo vệ sinh, làm sạch hoàn toàn vết rách da, trầy xước hoặc bỏng bị nhiễm bẩn và thực hiện ăn chín uống chín…
Trong thời gian gần đây, tại một số địa phương có ghi nhận rải rác các trường hợp mắc bệnh Whitmore và dự báo sẽ tiếp tục ghi nhận thêm các trường hợp mắc trong thời gian tới ở nhiều địa phương, nhất là tại các khu vực có điều kiện vệ sinh môi trường bị ô nhiễm, là điều kiện thuận lợi cho vi khuẩn sinh sôi, phát triển.
Ngày 10/11, Cục Y tế dự phòng ban hành Công văn khẩn gửi Sở Y tế tỉnh Thanh Hóa và Sở Y tế tỉnh Đắk Lắk đề nghị Sở Y tế quan tâm chỉ đạo thực hiện một số nội dung trọng tâm để chủ động phòng chống hiệu quả đối với bệnh Whitmore trên địa bàn các tỉnh, cụ thể như sau:
Tăng cường giám sát chặt chẽ tình hình bệnh Whitmore (bệnh Melioidosis), thực hiện lấy mẫu xét nghiệm các trường hợp nghi ngờ và các đối tượng nguy cơ cao để phát hiện sớm các trường hợp mắc và xử lý điều trị trên địa bàn tỉnh, nhất là tại các vùng nguy cơ cao, đã có bệnh nhân mắc bệnh Whitmore. Tổ chức thu dung, cấp cứu bệnh nhân, điều trị tích cực để hạn chế thấp nhất các trường hợp tử vong do bệnh Whitmore.
Chỉ đạo các đơn vị y tế tổ chức điều tra, phân tích về dịch tễ các trường hợp mắc bệnh Whitmore, phân tích nguy cơ và triển khai các biện pháp phòng chống bệnh Whitmore.
Phối hợp với cơ quan truyền thông đẩy mạnh các hoạt động tuyên truyền về nguy cơ mắc và các biện pháp phòng chống bệnh Whitmore để người dân hiểu và chủ động thực hiện các biện pháp phòng chống; đưa các trường hợp nghi ngờ bị mắc bệnh đến ngay các cơ sở y tế để được khám và điều trị, đặc biệt chú ý đối với các đối tượng nguy cơ cao mắc bệnh Whitmore.
Chỉ đạo các đơn vị y tế thực hiện báo cáo dịch bệnh theo quy định và tổng hợp báo cáo gửi về Bộ Y tế (Cục Y tế dự phòng).
Thông tin chung về bệnh Whitmore
Bệnh Whitmore (tên gọi khác là bệnh Melioidosis) là một bệnh nhiễm trùng ở người và động vật do vi khuẩn Burkholderia Pseudomalle gây ra. Vi khuẩn B. pseudomallei sống trong đất, nước bị nhiễm khuẩn và xâm nhập vào cơ thể chủ yếu qua da khi có vết thương hở tiếp xúc trực tiếp với đất, nước bị nhiễm khuẩn B. pseudomallei. Hiện chưa có bằng chứng về việc lây truyền vi khuẩn từ người sang người hoặc từ động vật sang người. Bệnh Whitmore là bệnh không thường gặp, không lây lan thành dịch. Bệnh ghi nhận số mắc cao chủ yếu tại Úc và khu vực Đông Nam Á.
Tại Việt Nam, ca bệnh đầu tiên được ghi nhận vào năm 1925 tại TP. Hồ Chí Minh, sau đó xuất hiện rải rác ở một số địa phương. Bệnh có biểu hiện lâm sàng rất đa dạng, khó chẩn đoán và có thể tử vong nếu không được chẩn đoán và điều trị kịp thời, đặc biệt ở những người có bệnh nền như tiểu đường, bệnh gan, thận, phổi mạn tính, suy giảm miễn dịch … Bệnh được điều trị bằng cách sử dụng các kháng sinh có nhạy cảm với các chủng B. pseudomallei và điều trị các triệu chứng, biến chứng kèm theo, đồng thời chăm sóc, điều dưỡng phục hồi sức khỏe cho người bệnh. Hiện chưa có vaccine phòng bệnh Whitmore.
Bộ Y tế khuyến cáo người dân chủ động phòng bệnh Whitmore như sau:
1) Đảm bảo vệ sinh cá nhân, thường xuyên rửa tay với xà phòng và nước sạch, đặc biệt là trước và sau khi chế biến thức ăn, sau khi đi vệ sinh, sau khi đi làm ruộng, trước khi ăn.
2) Thực hiện ăn chín, uống nước đun sôi để nguội, đảm bảo vệ sinh an toàn thực phẩm; không giết mổ, ăn thịt động vật, gia súc, gia cầm bị ốm chết.
3) Hạn chế tiếp xúc trực tiếp với đất, nước bẩn, đặc biệt tại những nơi bị ô nhiễm nặng. Không tắm gội, bơi, ngụp lặn ở các ao, hồ, sông tại/gần nơi bị ô nhiễm.
4) Sử dụng đồ bảo hộ lao động (giày, ủng, găng tay…) đối với những người thường xuyên việc ngoài trời, tiếp xúc với đất và nước bẩn.
5) Khi có vết thương hở, vết loét hoặc vết bỏng cần tránh tiếp xúc với đất hoặc nước có khả năng bị ô nhiễm. Nếu bắt buộc phải tiếp xúc thì sử dụng băng chống thấm và cần được rửa sạch đảm bảo vệ sinh.
6) Những người có bệnh nền như tiểu đường, bệnh gan, thận, phổi mạn tính, suy giảm miễm dịch… cần được chăm sóc, bảo vệ các tổn thương để ngăn ngừa nhiễm khuẩn.
7) Khi nghi ngờ nhiễm bệnh cần đến cơ sở y tế để được tư vấn, khám phát hiện và điều trị kịp thời.
Lifehub tổng hợp
Nguồn bài viết